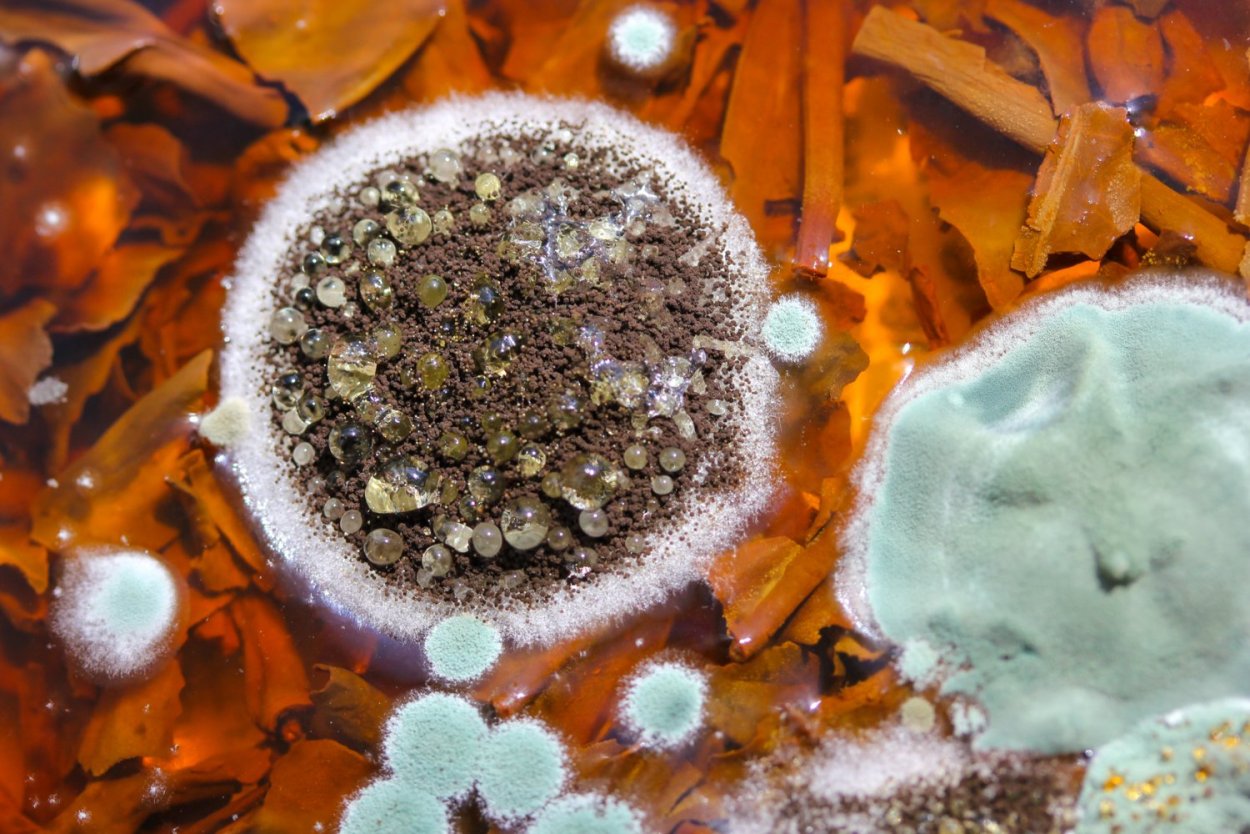
Плесневые грибы грибы
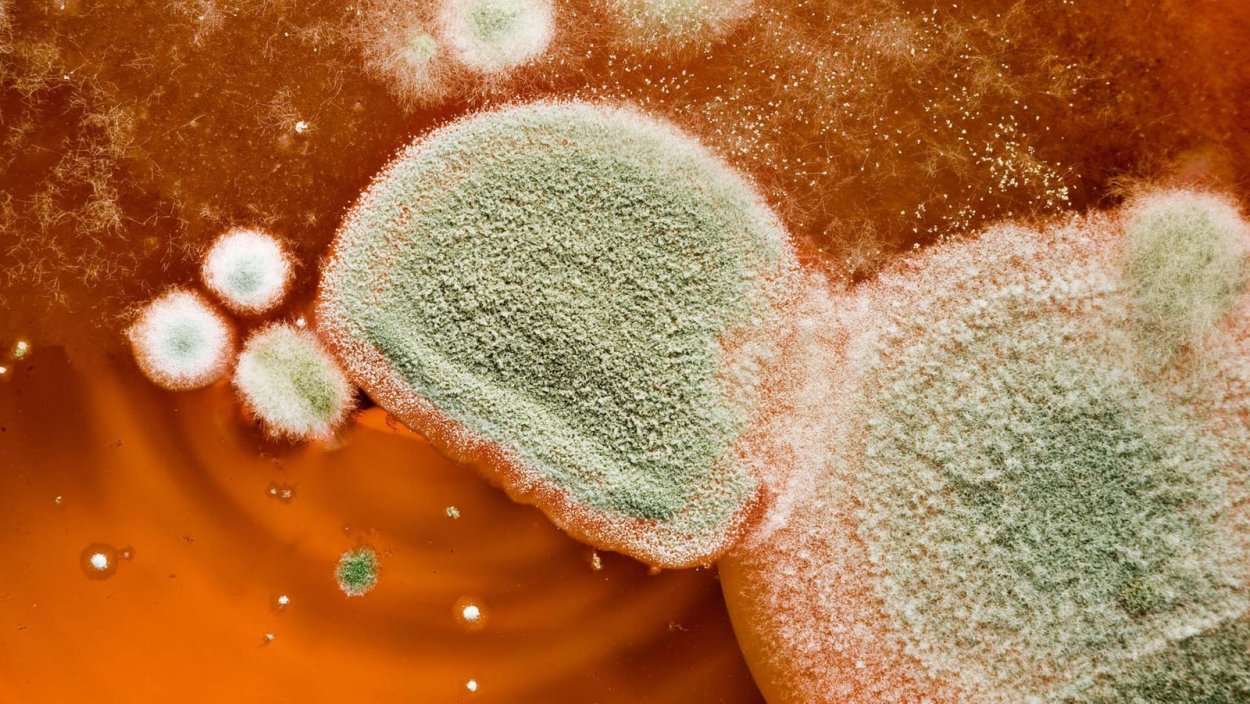
Плесневые грибы на еде
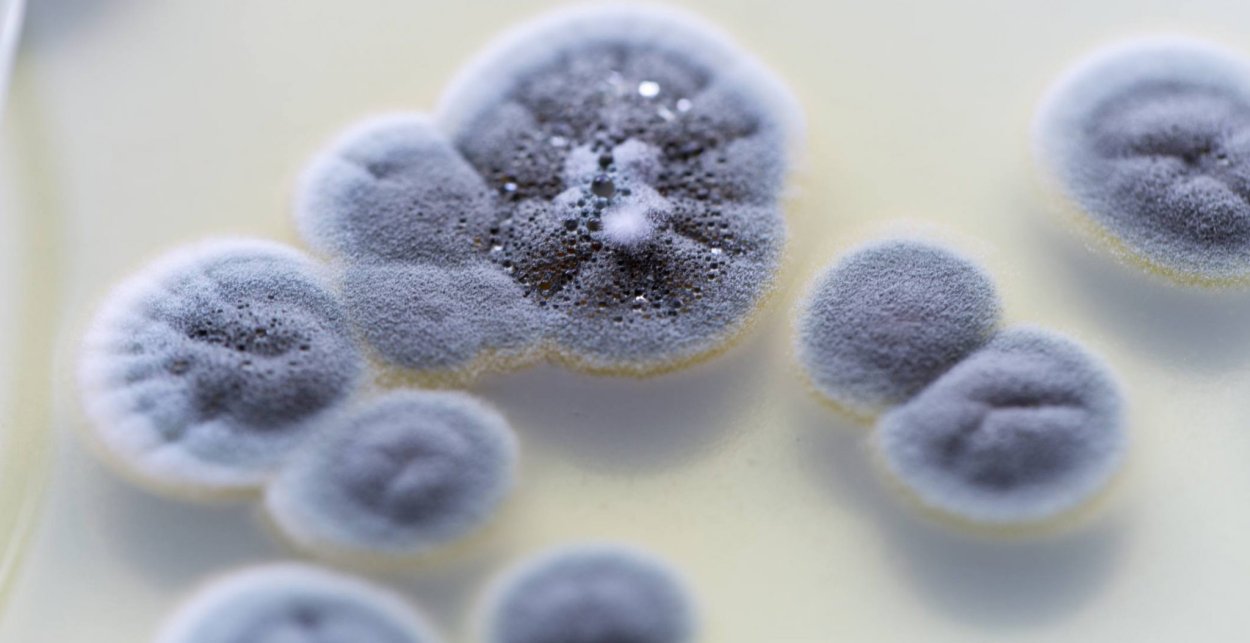
Антибиотики из плесени
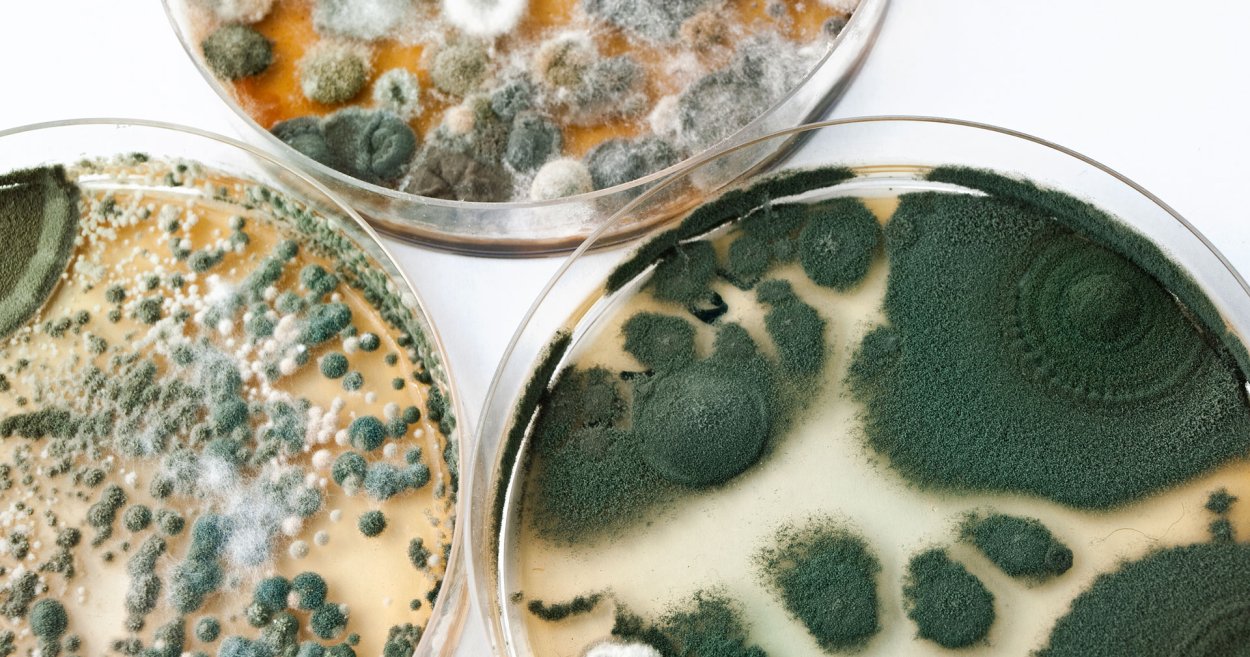
Пищевая плесень
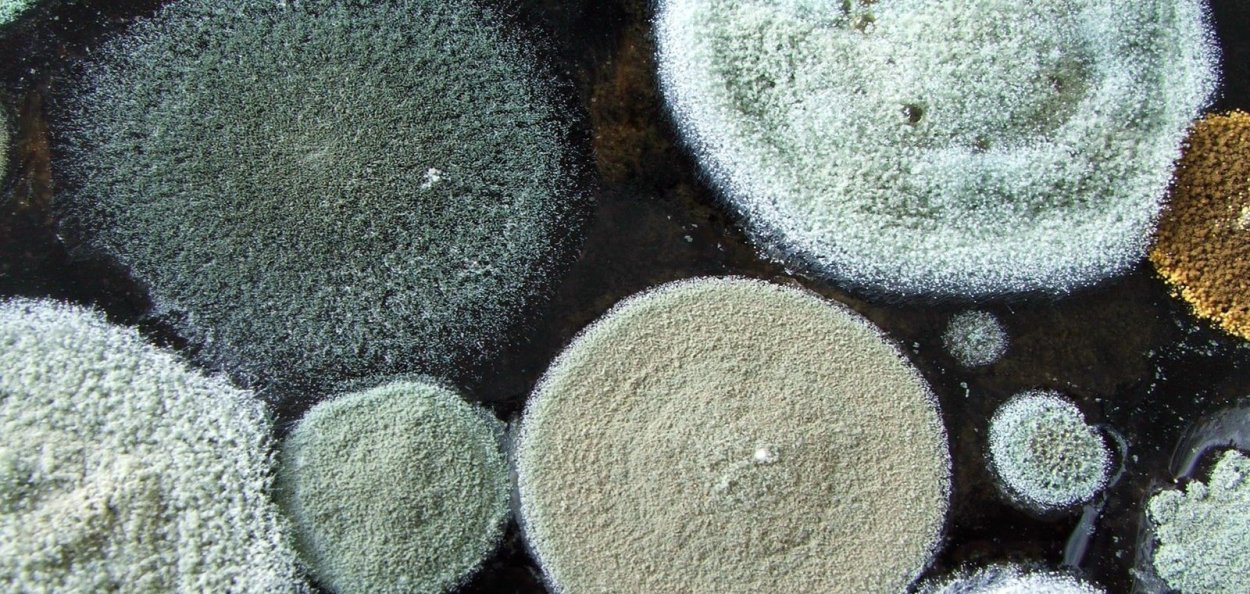
Микология плесень
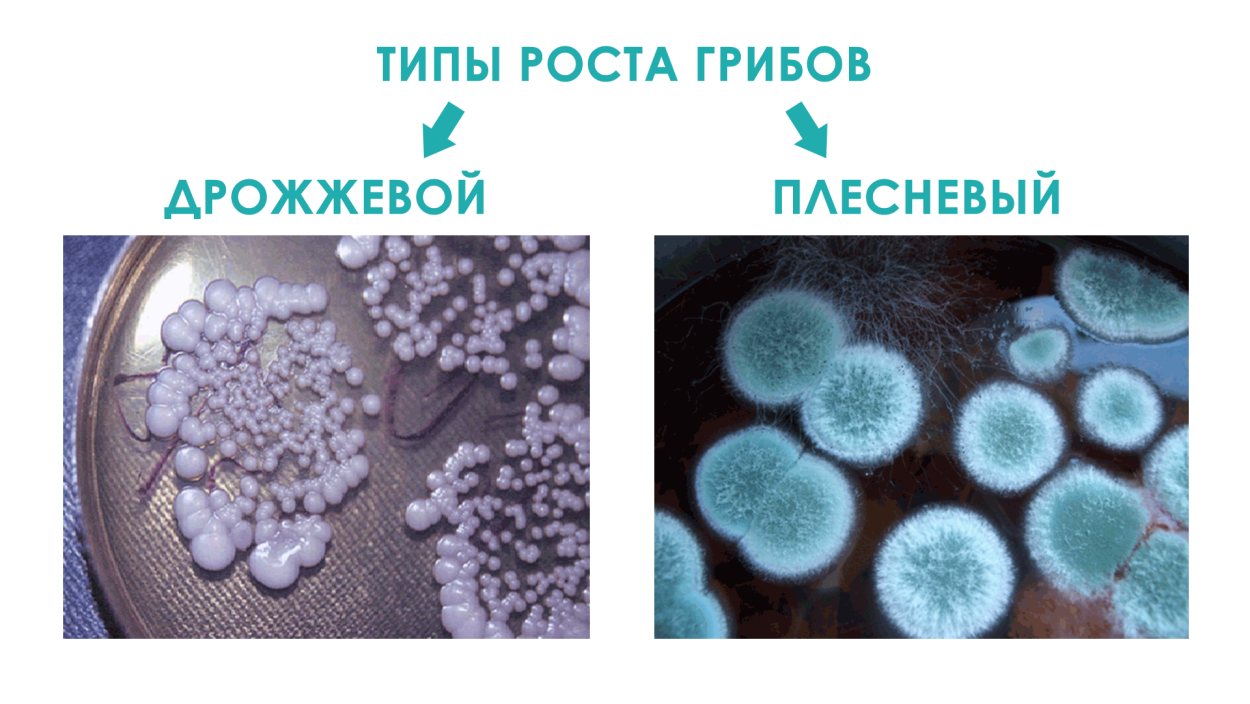
Грибок кандида плесневые грибы

Плесневелые грибы виды

Плесневые грибы Mucor

Зеленая плесень пеницилл

Меловая болезнь хлеба

Белый грибок чашка Петри

Грибы мукор пеницилл дрожжи

Aspergillus flavus Токсин

Микробиология Penicillium Aspergillus

Зигомицеты мукор

Плесень аспергилл черный

Плесневые грибочки

Плесень Макросъемка

Микроскопические грибы fungi

Грибы фузариум конидиеносцы

Красивая плесень

Микотоксины Penicillium

Плесень на стенах
Плесневые грибы грибы

Гриб пеницилл на хлебе

Белая плесень мукор
Плесневые грибы на еде

Ризопус мицелий

Черный грибок мукоромикоз

Грибы плесневые, Шапочные, дрожжи
Антибиотики из плесени

Плесневые грибы спорангии
Пищевая плесень

Плесени/плесневые грибы

Гриб мукор и пеницилл

Плесень Макросъемка

Плесневые грибы аспергиллус

Микроскопические грибы Aspergillus flavus

Гриб пеницилл под микроскопом

Плесневые грибки

Грибы плесень

Плесень мукор

Плесневые грибы ризопус

Плесень паутинка

Cladonia floerkeana кладония

Плесневые грибы Mucor

Didymium squamulosum

Красивая плесень

Ризопус зигоспора

Бесшляпочные грибы

Серая плесень под микроскопом

Гриб пеницилл плесень на хлебе

Wallemia плесень

Одноклеточные грибы пеницилл

Гриб мукор на хлебе

Белая плесень мукор

Цвет плесени

Rhizopus nigricans

Клетка гриба плесень мукор

Грибы плесень
Микология плесень

Плесневелые лишайники

Плесневые грибы грибы аспергилл

Дрожжи плесневые Шляпочные паразитические грибы

Плесневые грибы в жизни человека

Плесневые грибки

Ulocladium плесень

Мицелий мукора
Грибок кандида плесневые грибы

Плесневые грибы

Плесень гриб мукор

Грибы